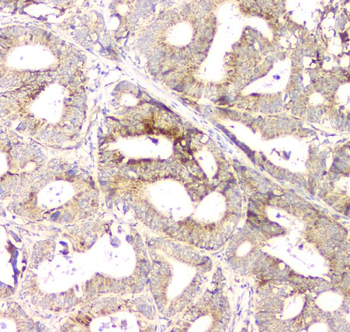
Aprt Rabbit Polyclonal Antibody

You have no items in your shopping cart.
All Products
- Beclin 1/BECN1 Rabbit Polyclonal Antibody [orb196247]
FC, ICC, IF, IP, WB
Human, Mouse, Rat
Rabbit
Polyclonal
Unconjugated
100 μg - beta Amyloid/APP Rabbit Polyclonal Antibody [orb196261]
ICC, IF, IHC, WB
Human, Mouse, Rat
Rabbit
Polyclonal
Unconjugated
100 μg - PARP/PARP1 Rabbit Polyclonal Antibody [orb234355]
FC, ICC, IF, IHC, WB
Human, Mouse, Rat
Rabbit
Polyclonal
Unconjugated
100 μg - Hsp47/SERPINH1 Rabbit Polyclonal Antibody [orb234371]
IHC, WB
Human, Mouse, Rat
Rabbit
Polyclonal
Unconjugated
100 μg - Caveolin-1/CAV1 Rabbit Polyclonal Antibody [orb215919]
FC, IF, IHC, IHC-Fr, WB
Human, Mouse, Rat
Rabbit
Polyclonal
Unconjugated
100 μg - CD79b Rabbit Polyclonal Antibody [orb215923]
FC, IF, IHC, WB
Human, Mouse, Rat
Rabbit
Polyclonal
Unconjugated
100 μg FC, ICC, IF, IHC, IHC-Fr, WB
Human, Mouse, Rat
Rabbit
Polyclonal
Unconjugated
100 μg- SRI Rabbit Polyclonal Antibody [orb527008]
FC, ICC, IF, IHC, IHC-Fr, WB
Human, Mouse, Rat
Rabbit
Polyclonal
Unconjugated
100 μg - Aprt Rabbit Polyclonal Antibody [orb527015]
IHC, WB
Human, Mouse, Rat
Rabbit
Polyclonal
Unconjugated
100 μg - IQGAP1 Rabbit Polyclonal Antibody [orb527028]
ELISA, FC, ICC, IF, IHC, WB
Human, Mouse, Rat
Rabbit
Polyclonal
Unconjugated
100 μg